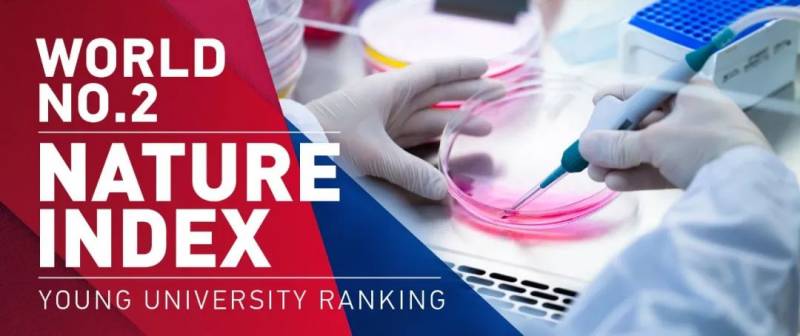

新加坡南洋理工大学中国内地本科招生流程介绍
南大本科课程在中国内地招生的对象为已经参加过高考或即将在 2020 年 6 月参加高考的学生。持中国高考学历的学生可凭高考成绩申请入学,应届高三生则须提交高一和高二成绩申请。
申请者另须呈交(其中一项):
• 托福(TOEFL)
• 雅思(IELTS)
• SAT
• PTE 学术英语考试 (PTE Academic)
• 美国大学入学考试包含作文测试(ACT with Writing)
• 安生(AMESON) 英语考试
符合基本入学条件并通过初审的申请者需要参加南洋理工大学的入学面试,以确定入学资格。面试通常于3 月下旬举行。只有获邀参加面试的申请者会通过电邮得到有关面试日期、时间和地点等信息。申请结果将于4月下旬至 5月上旬间公布。

基本学术与英语水平入学要求
学术成绩
• 已参加高考:高考分数达到一本线;
• 未参加高考( 在籍高三生):优异的高一和高二成绩;
• 安生世界名校英才遴选暨育工程(ACEIS):如有参加英文、数学、物理考试可直接通过安生报名。
英语水平(其中一项)
• 托福(TOEFL) – 网络考试 iBT至少90分或笔试pBT至少600分;
• 雅思(IELTS) – 总分至少6.0;
• SAT – 总分至少1900 (2018年三月前考取)或1250(2017年改革后新 SAT);
• PTE学术英语考试 (PTE Academic) – 总分至少55 ;
• 安生 (AMESON) 英语考试 – 至少140 分;
• ACT考试包含作文测试 (ACT with Writing) – 总分至少30分。
符合报名条件的申请者可在 2019年10月15日至 2020年3月19日在南大招生处网站进行网上报名。南大并无指定任何中介或机构代理本科入学事宜,如有任何查询,请直接电邮南大招生处: [email protected]
注:申请者提交的托福(TOEFL) 或雅思(IELTS)或 PTE学术英语考试(PTE Academic)成绩必须是在 2018年1月15日至2020年1月15日内所考取。SAT与 ACT有效期为 5年。
所有国际学生在注册成为南洋理工大学学生前须完成12年基础教育。取得我校入学资格的中国学生必须在注册为我校学生前完成高中三年学习并呈上高中毕业证书。
凭其他学历申请的学生,请参阅其他学历的申请入学要求。

2019-2020 学年学费
+ 领取新加坡教育部津贴(Tuition Grant)的外籍学生(包括新加坡永久居民)毕业后,需为新加坡注册公司服务 3 年。
2019-2020 学年的学费有待调整。有关学费的信息以英文网站公布的为准:
http://www.ntu.edu.sg/NSS/NSSFinance/FeesTuitionGrant/Pages/TuitionFees.aspx

2019-2020 学年杂费
每月花费估计
您可通过以下连结,估计您的财务需要:
https://wis.ntu.edu.sg/webexe/owa/vical.showvical
2020学年入学申请程序
请详细阅读以下说明之后才点击第六项的连结登入网上申请系统。
一、确认申请资格
以下信息仅适用于持中国高考学历的申请者,持其他国际学历学生,请点击文末“阅读原文”参阅详情。在籍高三生(即将在2020年6月参加高考学生)或往届生(已参加过高考)可申请2020学年本科课程。每位申请者只能提交一份申请表格。
二、申请编号与确认邮件
申请者完成网上申请后会取得一个申请编号及收到我处发出的确认邮件,并同时会进入“查询申请进度”(Check Status)页面,申请者可在该页面看到须继续完成的项目。
三、缴交申请费
国际学生的申请费为新币30元或美金30元。如以信用卡支付则只需付新币20元。新加坡公民或永久居民的申请费为新币10元。申请者可通过以下方式缴交申请费:
• 通过信用卡(VISA威士或MasterCard万事达)在网上付款;
• 汇票(汇票收款人请注明‘Nanyang Technological University’,申请者须在汇票背面 清楚写明入学申请编号及英文姓名。申请者须将银行汇票正本邮寄至我处);
• 在新加坡的星展银行或储蓄银行自动提款机付款;
• 在南洋理工大学One Stop @ SAC以无现金方式, 如NETS卡、现金卡(Cash Card)、 信用卡(Credit Card) or 易通卡 (Ez-Link Card) 付款。
请详细阅读文末“阅读原文”中的连结进入“查询申请进度”(Check Status)页面的“申请费”项目中的付款说明。无论申请结果成功与否,申请费恕不退还。
我校不接受下列付款方式:银行电汇付款、邮政汇票(除了新加坡邮政发出的邮政汇票外)、西联(Western Union)汇款。

NTU列泰晤士高等教育排名第48位
四、准备申请材料
1. 在籍高三生(将在 2020年6月参加高考学生)
• 护照个人资料页。新加坡公民与永久居民须呈交新加坡身份证 (正反面)。尚未取得护照的外国申请者可呈交出生证明或户籍证明;
• 中文申请表格(可在完成网上申请后在“查询申请进度” (Check Status)页面下载);
• 中考成绩 。
• 高一和高二在校成绩与最近一次高三模拟考成绩(若有);
• 安生 AST考试成绩(若有);
• 托福(TOEFL) 或雅思(IELTS)或 SAT1或 PTE学术英语考试(PTE Academic)成绩单或 ACT 考试包含作文测试(ACT with Writing);
• CollegeBoard Advanced Placement (AP) 成绩单(若有)。
2. 在籍大学生/已参加过高考的学生
• 护照个人资料页。新加坡公民与永久居民须呈交新加坡身份证 (正反面)。尚未取得护照的外国申请者可呈交出生证明或户籍证明;
• 中文申请表格(可在完成网上申请后在“查询申请进度”页面下载);
• 中考成绩;
• 高考成绩;
• 高中毕业证书;
• 大学成绩(若有);
• 安生 AST考试成绩(若有);
•托福(TOEFL) 或雅思(IELTS)或 SAT1或 PTE学术英语考试(PTE Academic)成绩单或 ACT 考试包含作文测试 (ACT with Writing);
• CollegeBoard Advanced Placement (AP) 成绩单(若有)。
注:申请者提交的托福(TOEFL) 或雅思(IELTS)或 PTE学术英语考试(PTE Academic)成绩单必须是在2018年1月15日至 2020年1月15日内所考取。SAT1与 ACT 考试包含作文测试 (ACT with Writing)有效期为 5年。
选择“艺术、设计与媒体”(Art, Design & Media)专业的学生须呈交额外材料。有关该专业的入学材料要求,请参考文末“阅读原文”中艺术、设计与媒体学院网站链接进入了解。
五、呈交申请材料
申请者须于2020年3月19日前提交相关的证明文件以完成申请流程。否则,此次申请将被视为无效申请。
为简化申请流程,我们强烈建议您使用在线上传功能 (通过“查询申请进度” Check Status页面登入清单 Checklist) 提交您的相关证明文件(除申请艺术媒体与设计课程项目所需提供的额外文件外)。可直接上传原件彩色扫描。学业成绩的复印件则必须拥有就读学校老师/校长或受委任人员的认证,方为有效。如若上传证明文件成功,无需再次通过邮件或电邮提交。如若正式录取,您需要提供所提交证明文件的原件,以供验证。
为成功上传证明文件至清单(Checklist),请注意以下几点:
• 请确认所有的扫描文件为微软 word格式(插入图片文件,复制与粘贴将不被接受)或PDF格式。
• 请将所有归属于同一份文件的页面归并保存成一份文件,并作为一份文件上传至相应位置。
• 请确认文件上传至其相应的正确位置。一经上传,文件将无法修改或被浏览。
• 请确认提交所有归属于“必须上传”的文件。
• 成功上传所有文件后,请点击页面底部的“确认” (Confirm)按键以确认完成上传文件。不完整的申请将被视为无效申请。
注意:请确认在点击“确认”(Confirm)按键之前已上传所有所需/可提供的文件。一经“确认”, 将无法更改浏览上传的文件清单。如若需要帮助,请通过[email protected] 联系我们。
如若无法在线上传文件,请打印清单(Checklist)作为所提交文档的封面,根据清单中的顺序排列申请材料,寄至以下地址:
Office of Admissions,
Nanyang Technological University,
Student Services Centre, #03-01,
42 Nanyang Avenue Singapore 639815
学业成绩的复印件必须拥有就读学校老师/校长或受委任人员的认证,方为有效。请在提交的每页文件的右上角与信封的左上角注明您的申请编号。请勿邮寄文件原件。
六、提交网上申请表格
2020年7月末入学将在2019年10月15日至2020年3月20日开放申请。请复制/粘贴以下连结登入网上申请系统,或者去“阅读原文”处找到相应连结进入。
admissions.ntu.edu.sg/UndergraduateIntnlAdmissions/Pages/PRCNCEE_apply.aspx
七、查询申请结果或更新申请资料
我校会通过邮件和网上查询系统通知申请结果。符合基本入学条件并通过初审的申请者需要参加南洋理工大学的入学面试,以确定入学资格。申请者可在“查询申请进度” (Check Status)页面:
(1) 查询申请材料呈交状态、申请费付款状态;
(2) 于申请开放期间更新专业选择和个人联系资料;
(3)于申请开放期间呈交奖学金申请表格 ;
(4) 查询申请结果。

NTU驻中国办公室联络信息
上海办公室
地址:上海太仓路233号新茂大厦306室
电话:(86-21) 5262-0616
电子邮箱:[email protected]
北京办公室
地址:北京海淀丹棱街3号中国电子大厦B座1602室
电话:(86-10)8260-7665
电子邮箱:[email protected]
广州办公室
地址:广州市黄埔区中新广州知识城九龙大道腾飞园腾飞二街11号(B4栋)
电话:(86-20)8203-5581
电子邮箱:[email protected]
严正声明:
新加坡南洋理工大学未指定任何中介或机构代理本科入学事宜,如有任何查询,请直接电邮南大招生处:
[email protected]
最后
祝各位小鲜肉小仙女申请顺利!

本文数据和图片来源于NTU官网
关注南洋理工小助手
更多精彩不定期更新

感谢关注新加坡最大留学生自媒体!
评论